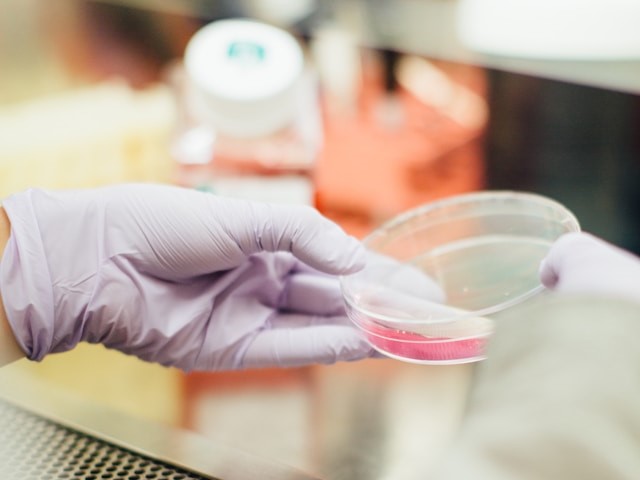

A döntőn a csapatok teljesítményét értékelő szakértő zsűri tagjai Dr. Csapody Bence, szállodavezető, turisztikai-vendéglátási tanácsadó, egyetemi kutató és oktató, Dr. László Veronika, tudományos segédmunkatárs, az Innovációmenedzsment Intézeti Tanszék munkatársa és Dr. habil. Domokos Endre, egyetemi docens, a Bio-, Környezet- és Vegyészmérnöki Kutató Fejlesztő Központ vezetője, a Fenntarthatósági Megoldások Kutatólaboratórium munkatársa voltak.
Az országos versenyre összesen 58 háromfős csapat regisztrált, így közel 180 diák vett részt az online fordulón. Jelentkeztek csapatok Bajáról, Balatonfűzfőről, Budapestről, Győrből, Kaposvárról, Keszthelyről, Komáromból, Kőszegről, Nyíregyházáról, Pápáról, Székesfehérvárról, Várpalotáról és Veszprémből. A döntőre 10 csapat jutott tovább.
1. helyezett: a kőszegi Jurisich Miklós Gimnázium és Kollégium „Reciklikánusok” csapata, amelynek tagjai: Csuka Dániel, Macsinga Ákos, Sipos Eszter
2. helyezett: a győri Baksa Kálmán Két Tanítási Nyelvű Gimnázium „Zöldhasúak” csapata, amelynek tagjai: Kurtyák Samu, Szatzker Zoltán, Tanos Bálint
3. helyezett: a győri Baksa Kálmán Két Tanítási Nyelvű Gimnázium „EcoFlow” csapata, amelynek tagjai: Lajer Benedek, Papp Kármen, Rigó Jázmin